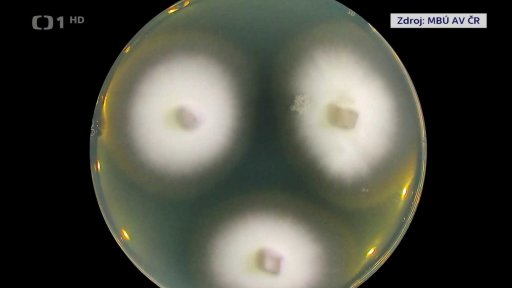
Houbové infekce

6. dubna
Část: Reakce přírody na klimatické změny
Obsah dílu
Headlines — Války prodražují stavební materiály — Dopad rotoucích cen na dopravní stavby — Dopravní stavby v letošním roce — Peníze na dopravní stavby v regionech — Trump i Írán odmítli příměří navržené Pákistánem — Plán na příměří — Průměrné ceny pohonných hmot — Policejní kontroly během Velikonoc — Ruské útoky na Ukrajinu — Soud poslal do vazby dalšího obviněného kvůli požáru v Pardubicích — Nálože u plynovodu v Srbsku — Stíhání Steva Bannona — Lidé častěji nakupují potraviny online — Přibylo bankrotů — Celovečerní film o Komenském — Revize systému emisních povolenek — Posádku Artemis čeká oblet Měsíce — Lesní požár na Královéhradecku — Oslavy velikonočního pondělí — Houbové infekce — Dopravní problémy v Gotthardském tunelu — Škody kvůli podvodným telefonátům — Záchrana velryby v Německu — Debaty o dřívějších důchodech pro strážníky — Reakce přírody na klimatické změny — Návštěvy hradů a zámků — 80 let od vydání knihy Malý princ
Části dílu

Přehled dílů

8. dubna
Headlines — Dočasné příměří na Blízkém východě — Oboustranné příměří a otevření Hormuzu — Požadavky USA na Írán — Křehké příměří mezi USA a Íránem — Plány USA — Postoje Íránu k příměří — Hormuzský průliv — Reakce trhů — Cenové stropy — Palivové příplatky aerolinek — Účast prezidenta na summitu NATO — Bezpečnostní opatření firem z obranného průmyslu — Baron Prášil ve Stavovském divadle — Průzkumy před nedělními volbami v Maďarsku — Akce proti ruským hackerům — Prodej nových osobních automobilů — Ranní mráz a sázení brambor — Komplikace při dodávkách léků — Spotřeba léků v Česku — Co se vrací do lékárny — Látky z léků v přírodě — Svoboda volby rodičky — Podezření na podvod s evropskými dotacemi — 48 tun marihuany — Příběh generála Františka Peřiny — Požár budovy úřadu městské části Praha 15 — Kontrola hospodaření ČT — Investice do fotovoltaiky — Stavba posledního úseku dálnice D11 — Geneticky upravený ječmen — Mise Artemis II — Problémy s nepovolenými stavbami — Opravená Francisova turbína — Mezinárodní den Romů — Koncert České filharmonie

8. dubna
Znakový jazyk a skryté titulky
Znakový jazyk a skryté titulky

7. dubna
Headlines — Regulace trhu s pohonnými hmotami — Cenové stropy na benzin a naftu — Vývoj ceny ropy Brent — Vypršení ultimáta — Ultimátum Donalda Trumpa — Útok v Istanbulu — Schodek důchodového účtu — Nový náčelník generálního štábu — Velikonoční kontroly řidičů — Summit NATO — Maďarsko před volbami — Hi-tech architektura v Česku — Zadržení dalšího podeřelého kvůli útoku v Pardubicích — Peníze pro kulturu — Stížnost klienta kvůli špatnému zacházení — Obchodníkům rostou tržby — Tající sníh plní řeky — Západ planety Země — Krátery na povrchu Měsíce — Přímý přenos z mise — Česká stopa na misi — Návrh na energetické příměří — Včasná diagnostika rakoviny slinivky — Prezident na návštěvě Brna — Vyšetřování policistů z oddělení v Domašově — Nehoda TGV — Trest za vraždu bývalé přítelkyně — Nehoda autobusu na Znojemsku — Pád kamenu ze skály v Krkonoších — Stavba metra D — Zadržení australského válečného veterána — Drony pro zemědělce — Desítky netopyrů v Plzni

7. dubna
Znakový jazyk a skryté titulky
Znakový jazyk a skryté titulky

6. dubna
Headlines — Války prodražují stavební materiály — Dopad rotoucích cen na dopravní stavby — Dopravní stavby v letošním roce — Peníze na dopravní stavby v regionech — Trump i Írán odmítli příměří navržené Pákistánem — Plán na příměří — Průměrné ceny pohonných hmot — Policejní kontroly během Velikonoc — Ruské útoky na Ukrajinu — Soud poslal do vazby dalšího obviněného kvůli požáru v Pardubicích — Nálože u plynovodu v Srbsku — Stíhání Steva Bannona — Lidé častěji nakupují potraviny online — Přibylo bankrotů — Celovečerní film o Komenském — Revize systému emisních povolenek — Posádku Artemis čeká oblet Měsíce — Lesní požár na Královéhradecku — Oslavy velikonočního pondělí — Houbové infekce — Dopravní problémy v Gotthardském tunelu — Škody kvůli podvodným telefonátům — Záchrana velryby v Německu — Debaty o dřívějších důchodech pro strážníky — Reakce přírody na klimatické změny — Návštěvy hradů a zámků — 80 let od vydání knihy Malý princ

6. dubna
Znakový jazyk a skryté titulky
Znakový jazyk a skryté titulky

5. dubna
Headlines — Plynové zásobníky se vyprazdňují — Ceny plynu na světových trzích — Trumpův vulgární vzkaz Íránu — Trump hrozí Íránu ničením mostů a elektráren — Íránské útoky na státy Perského zálivu — Přípravy rozpočtu na příští rok — Týden do voleb v Maďarsku — Křesťané si připomínají vzkříšení Ježíše Krista — Poselství papeže Městu a světu — Ruské útoky v době začínajících Velikonoc na Ukrajině — Letošní počet maturantů — Výstava u hudebním publicistovi Jiřim Černém — Další zadržení kvůli žhářskému útoku v Pardubicích — Debaty o změně zákazů prodeje o svátcích — Mise Artemis pořídila nové snímky Měsíce — Výměna občanských průkazu po revoluci — Dosud nejteplejší letošní den — Rostoucí poptávka po elektromobilech — Prodeje aut s různými pohony — Vláda ruší výhody pro elektromobily — Invazivní druhy v české přírodě — Dlouhodobé spoření dětem — Policejní kontroly během Velikonoc — Omezení hlučných prací v neděli a o svátcích v Příbrami — Pád stromu v Německu — Paliativní péče v psychiatrické nemocnici Bohnice — Vývoj tržeb v osobním prodeji v ČR — Požár lesa u obce Dolany na Náchodsku — Parní úzkokolejka na německé Rujáně — Bezplatný vstup do některých galerií

5. dubna
Znakový jazyk a skryté titulky
Znakový jazyk a skryté titulky

4. dubna
Headlines — Summit NATO — Čeští zástupci na summitu NATO — Závazek vůči NATO — Ameické výdaje na obranu — Nátlak Donalda Trumpa na Írán — Volodymyr Zelenskyj v Turecku — Filip Turek v radě SFŽP — Bourání mostu v Hodoníně — Bourání mostu na D11 — Ruský dronový útok — Škody po bouři Eminio v Itálii — Blokování VPN — Výuka hraní na nástroje s pomocí umělé inteligence — Plánované změny v ochraně dětí — Značení turistických stezek — Povodně v roce 2006 zasáhly stovky obcí — Zájem o autolakýrnické obory — Vykradené bankomaty — Vyšetření kožních znamének — Otvírání hradů a zámků — Jarní turistickou sezonu na Dalešické přehradě — Končí lyžařská sezona — Polovina taxikářů v Česku je z ciziny — Mise Artemis II — Plán posílat bezdětné ženy v Rusku k psychologovi — Bílá sobota — Řezbář v Bechyni vyrábí velikonoční betlém — Revize fotovoltaických elektráren — Nová databáze radí chovatelům ptáků

4. dubna
Znakový jazyk a skryté titulky
Znakový jazyk a skryté titulky



